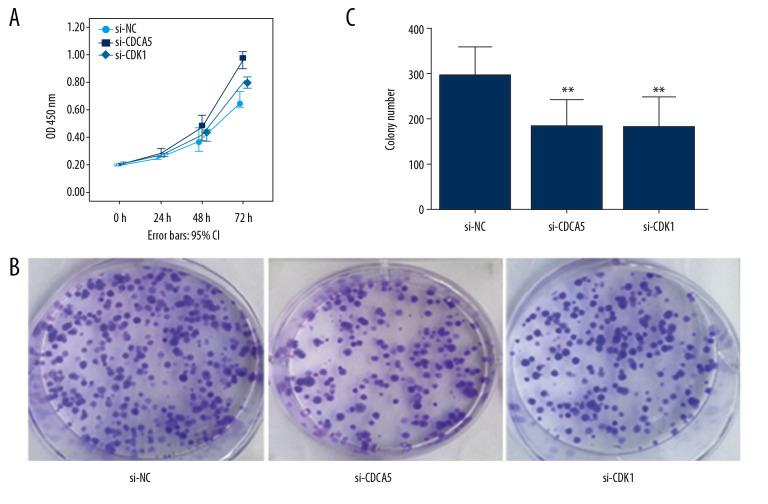
https://cdn.ncbi.nlm.nih.gov/pmc/blobs/54f2/7431384/51ce7f2847dd/medscimonit-26-e923664-g006.jpg

细胞周期蛋白依赖性激酶1(CDK1)与细胞分裂周期相关蛋白5(CDCA5)共表达:它们在胃癌细胞系MGC-803中的作用
Cyclin-Dependent Kinase 1 (CDK1) is Co-Expressed with CDCA5: Their Functions in Gastric Cancer Cell Line MGC-803.
作者信息
Huang Zhigang, Zhang Shizhuo, Du Jinlin, Zhang Xing, Zhang Weijian, Huang Zhaowei, Ouyang Ping
机构信息
Department of Epidemiology and Health Statistics, School of Public Health, Guangdong Medical University, Dongguan, Guangdong, China (mainland).
Guangdong Provincial Key Laboratory of Medical Molecular Diagnostics, Dongguan Scientific Research Center, Guangdong Medical University, Dongguan, Guangdong, China (mainland).
出版信息
Med Sci Monit. 2020 Aug 6;26:e923664. doi: 10.12659/MSM.923664.
BACKGROUND Gastric cancer (GC) is a worldwide malignancy and the molecular mechanism of the GC carcinogenesis has not been fully elucidated. Our previous study suggested CDCA5 played a role in GC development via regulating cell proliferation, migration, and apoptosis in GC cells. MATERIAL AND METHODS Here, we first carried out bioinformatics analysis and found cyclin-dependent kinase 1 (CDK1) was possibly associated with CDCA5 using STRING. Then, the expression levels of CDK1 and CDCA5 in cancer tissues were estimated through Oncomine and The Cancer Genome Atlas (TCGA) database. After that, functional experiments were exerted to detect the association of CDK1 and CDCA5. Finally, cell proliferation assay, colon formation assay, cell scratch assay, transwell migration and invasion assays were applied to explore the roles of CDK1 and CDCA5 in GC cells MGC-803. RESULTS CDK1 and CDCA5 were both upregulated and co-expressed in GC tissues. The expression of CDK1 and CDCA5 in MGC-803 was positively related. CDK1 or CDCA5 inhibition can suppress the proliferation, colon formation, migration, and invasion abilities of GC cells. CONCLUSIONS Co-expression of CDK1 and CDCA5 might confer cell proliferation, migration, and invasion abilities in GC cells, and this can provide some clues for further therapies of gastric tumors.
背景 胃癌(GC)是一种全球性恶性肿瘤,其致癌的分子机制尚未完全阐明。我们之前的研究表明,CDCA5通过调节胃癌细胞的增殖、迁移和凋亡在胃癌发生发展中发挥作用。材料与方法 在此,我们首先进行生物信息学分析,使用STRING发现细胞周期蛋白依赖性激酶1(CDK1)可能与CDCA5相关。然后,通过Oncomine和癌症基因组图谱(TCGA)数据库评估癌组织中CDK1和CDCA5的表达水平。之后,进行功能实验以检测CDK1与CDCA5之间的关联。最后,应用细胞增殖实验、集落形成实验、细胞划痕实验、Transwell迁移和侵袭实验来探究CDK1和CDCA5在胃癌细胞MGC-803中的作用。结果 CDK1和CDCA5在胃癌组织中均上调且共表达。MGC-803中CDK1和CDCA5的表达呈正相关。抑制CDK1或CDCA5可抑制胃癌细胞的增殖、集落形成、迁移和侵袭能力。结论 CDK1和CDCA5的共表达可能赋予胃癌细胞增殖、迁移和侵袭能力,这可为胃癌的进一步治疗提供一些线索。